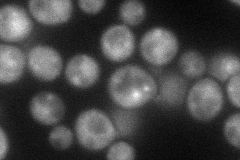
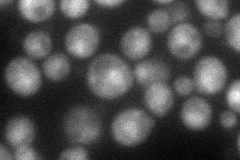
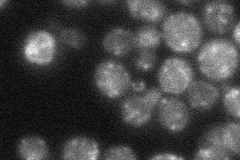

View description
Component of the conserved oligomeric Golgi complex (Cog1p through Cog8p), a cytosolic tethering complex that functions in protein trafficking to mediate fusion of transport vesicles to Golgi compartments
Localization:
Intensity:
Fold change:
Significance:
-
C’ GFP library in SD

punctate33.42 -
N' NOP1pr-GFP in SD
cytosol,punctate54.9831 -
N' TEF2pr-mCherry in SD
cytosol,nucleus49.6361 -
N' NATIVEpr-GFP in SD
punctate26.668 -
N' TEF2pr-VC and Cyto-VN in SD

cytosol37.4523 -
C’ GFP library in SD+DTT

punctate39.131.17No -
C’ GFP library in SD+H2O2

punctate30.790.92No -
C’ GFP library in Starvation Media

punctate26.920.8No -
C’ GFP library on the background of Pup2-DaMP

punctate -
C’ GFP library on the background of CCT mutant

punctate32.22540.964037No
